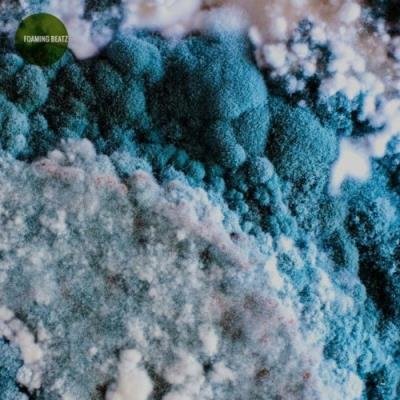
Foaming Beatz (2022)

Foaming Beatz (2022)
Исполнитель: VA
Название: Foaming Beatz (2022)
Жанр: Minimal, Tech House
Год выпуска: 2022
Количество треков: 12
Время звучания: 01:22:41
Формат: MP3
Качество: 320kbps
Размер: 191 MB
Треклист:
01. Luc Canetti — Brasswork [06:38] 02. Raumlehre — Exoplanet [06:40] 03. Modulest — Hydraulic Lines [06:55] 04. Dan Rubell — First Serve [07:13] 05. Joyzito — Oversight [06:44] 06. Datenbahn — Lead Section [06:47] 07. Seka Protectors — Over Revving [06:48] 08. Clique Rouge — Wave Particle [06:43] 09. Quadrumana — Free Circulation [07:21] 10. Walter Kurtz — Evolving Psychosis [06:57] 11. Licata & Linares — Inbound Route [06:47] 12. 2W Tools — Meeting in Progress [07:08]






